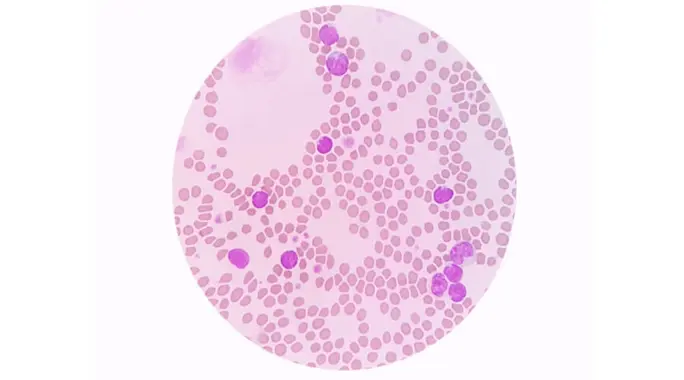

هل تلقيت مؤخرًا نتائج تحليل دم أظهرت ارتفاع الخلايا اللمفاوية؟ قد تشعر بالقلق وتتساءل عن معنى ذلك وما إذا كان مؤشرًا على مشكلة صحية خطيرة.
إن ارتفاع هذه الخلايا، وهي جزء أساسي من جهاز المناعة، غالبًا ما يشير إلى أن جسمك يخوض معركة ضد عدوى أو مرض ما. في هذا الدليل الشامل، سنستكشف سويًا ما هو ارتفاع الخلايا اللمفاوية، أسبابه الشائعة، أعراضه، وكيف يتم تشخيصه وعلاجه بفعالية. هيا بنا نتعمق في فهم هذه الحالة الطبية الشائعة.
- ما هو ارتفاع الخلايا اللمفاوية؟
- أسباب ارتفاع الخلايا اللمفاوية
- أعراض ارتفاع الخلايا اللمفاوية
- تشخيص ارتفاع الخلايا اللمفاوية
- مضاعفات ارتفاع الخلايا اللمفاوية
- علاج ارتفاع الخلايا اللمفاوية
- الوقاية من ارتفاع الخلايا اللمفاوية
- متى يجب استشارة الطبيب؟
- الخلاصة
ما هو ارتفاع الخلايا اللمفاوية؟
يُعرف ارتفاع الخلايا اللمفاوية، أو ما يُسمى طبيًا بـ “Lymphocytosis”، بزيادة عدد الخلايا اللمفاوية في مجرى الدم عن المعدل الطبيعي. هذه الحالة ليست مرضًا بحد ذاتها، بل هي مؤشر على أن جسمك يستجيب لشيء ما.
الخلايا اللمفاوية ودورها في الجسم
الخلايا اللمفاوية هي نوع حيوي من خلايا الدم البيضاء، وتشكل جزءًا لا يتجزأ من جهاز المناعة لديك. تتمثل وظيفتها الرئيسية في التعرف على العوامل المسببة للأمراض ومكافحتها، مثل الفيروسات والبكتيريا والخلايا السرطانية، مما يحمي الجسم من العدوى والالتهابات.
المستويات الطبيعية لعدد الخلايا اللمفاوية
تختلف المستويات الطبيعية للخلايا اللمفاوية بناءً على العمر. لدى البالغين، يعتبر وجود أكثر من 3000 خلية لمفاوية لكل ميكرولتر من الدم مؤشرًا على ارتفاعها. أما عند الأطفال، فقد يصل هذا العدد إلى 9000 خلية لمفاوية لكل ميكرولتر قبل أن يُصنف كارتفاع.
أسباب ارتفاع الخلايا اللمفاوية
يُعد ارتفاع الخلايا اللمفاوية استجابة طبيعية للجسم في كثير من الأحيان، وينتج عن عدة أسباب تتراوح بين البسيطة والمعقدة. تشمل أبرز هذه الأسباب ما يلي:
- العدوى: تُعد العدوى الفيروسية، مثل نزلات البرد والإنفلونزا والحصبة والتهاب الكبد، السبب الأكثر شيوعًا. كما يمكن أن تسبب العدوى البكتيرية أو الفطرية ارتفاعًا في عدد الخلايا اللمفاوية.
- الالتهابات المزمنة: الأمراض التي تسبب التهابًا مستمرًا وطويل الأمد، مثل التهاب المفاصل الروماتويدي أو داء كرون، قد تؤدي إلى ارتفاع مزمن في الخلايا اللمفاوية.
- ردود الفعل الدوائية: قد تحدث هذه الزيادة كاستجابة لبعض الأدوية الجديدة أو التفاعلات الدوائية.
- إزالة الطحال: الطحال يلعب دورًا في تصفية الخلايا اللمفاوية القديمة، لذا فإن إزالته يمكن أن تؤدي إلى ارتفاع مستمر في عددها.
- بعض أنواع السرطان: في حالات نادرة، يمكن أن يشير ارتفاع الخلايا اللمفاوية إلى وجود سرطانات معينة في الدم أو الجهاز اللمفاوي، مثل ابيضاض الدم (اللوكيميا) أو سرطان الغدد اللمفاوية.
أعراض ارتفاع الخلايا اللمفاوية
في كثير من الأحيان، لا يتسبب ارتفاع الخلايا اللمفاوية بحد ذاته في ظهور أي أعراض واضحة. غالبًا ما يُكتشف هذا الارتفاع بالمصادفة خلال فحوصات الدم الروتينية التي تُجرى لأسباب أخرى.
مع ذلك، قد تظهر الأعراض المرتبطة بالسبب الكامن وراء ارتفاع الخلايا اللمفاوية. يمكن أن تتراوح هذه الأعراض من خفيفة إلى شديدة، وتختلف بشكل كبير اعتمادًا على الحالة الصحية الأساسية. على سبيل المثال، قد تشعر بالتعب أو الحمى إذا كان السبب عدوى فيروسية.
تشخيص ارتفاع الخلايا اللمفاوية
لتشخيص سبب ارتفاع الخلايا اللمفاوية بدقة، سيبدأ طبيبك بمراجعة تاريخك الطبي المفصل والاستفسار عن أي أعراض قد تكون تعاني منها. سيتبع ذلك إجراء فحص بدني شامل لتقييم حالتك الصحية العامة.
الفحوصات الشائعة
تُعد فحوصات الدم هي الأداة الرئيسية لتأكيد وجود ارتفاع في الخلايا اللمفاوية وتحديد سببه. تشمل أبرز الفحوصات ما يلي:
- فحص تعداد الدم الكامل (CBC): هذا الفحص الروتيني يقيس مستويات جميع مكونات الدم، بما في ذلك الخلايا اللمفاوية، ويكشف عن أي ارتفاع غير طبيعي في عددها.
- فحص قياس التدفق الخلوي: يساعد هذا الفحص على تحليل خصائص الخلايا اللمفاوية لتحديد نوعها وتصنيفها، وهو أمر ضروري لتشخيص بعض الحالات الأكثر تعقيدًا مثل أنواع معينة من سرطان الدم.
في بعض الحالات، قد يرى الطبيب ضرورة لأخذ خزعة من نخاع العظم. تُستخدم هذه العينة لفحص الخلايا اللمفاوية بشكل مباشر وتساعد في تأكيد التشخيصات الصعبة أو استبعاد الأمراض الخطيرة.
مضاعفات ارتفاع الخلايا اللمفاوية
في أغلب الأحيان، لا يؤدي ارتفاع الخلايا اللمفاوية إلى مضاعفات مباشرة بحد ذاته. بدلًا من ذلك، هو إشارة واضحة إلى أن جهازك المناعي يعمل بجد لمكافحة تهديد صحي، عادة ما تكون عدوى فيروسية.
ومع ذلك، تكمن الخطورة في السبب الكامن وراء هذا الارتفاع. إذا كان الارتفاع ناتجًا عن حالة خطيرة مثل سرطان الدم أو اضطراب مناعي مزمن لم يُشخص بعد، فإن عدم اكتشاف وعلاج هذه الحالة الأساسية يمكن أن يؤدي إلى مضاعفات صحية جسيمة على المدى الطويل.
علاج ارتفاع الخلايا اللمفاوية
لا يُعالج ارتفاع الخلايا اللمفاوية بشكل مباشر، بل يركز العلاج على معالجة السبب الأساسي الذي أدى إلى هذا الارتفاع. بمجرد تشخيص الحالة المسببة، يبدأ الطبيب بوضع خطة علاجية مناسبة.
على سبيل المثال، إذا كانت العدوى الفيروسية هي السبب، فقد يوصي الطبيب بالراحة وتناول السوائل والسماح للجسم بالتعافي ذاتيًا. أما إذا كانت هناك عدوى بكتيرية، فربما تُوصف المضادات الحيوية. في حالات الأمراض المزمنة أو السرطانات، قد تتطلب الحالة علاجات أكثر تخصصًا.
في معظم الحالات، ومع تحسن الحالة الأساسية وعلاجها بنجاح، تعود مستويات الخلايا اللمفاوية تدريجيًا إلى معدلاتها الطبيعية، مما يؤكد أن الارتفاع كان استجابة مؤقتة لعملية الشفاء.
الوقاية من ارتفاع الخلايا اللمفاوية
نظرًا لأن ارتفاع الخلايا اللمفاوية غالبًا ما يكون مؤشرًا على استجابة الجسم لعدوى أو مرض، فلا توجد طريقة مباشرة “للوقاية” من الارتفاع نفسه.
ومع ذلك، يمكنك تقليل خطر الإصابة بالعديد من الحالات التي تسبب هذا الارتفاع، خاصة العدوى الفيروسية، من خلال اتباع ممارسات صحية جيدة:
- النظافة الشخصية: اغسل يديك بانتظام بالماء والصابون، خاصة بعد السعال أو العطس أو استخدام المرحاض وقبل الأكل.
- تجنب الاتصال: ابتعد عن الأشخاص المصابين بالعدوى قدر الإمكان، وتجنب لمس وجهك، خاصة عينيك وأنفك وفمك، لمنع انتشار الجراثيم.
- عدم مشاركة الأغراض: لا تشارك الأغراض الشخصية مثل الأكواب والأطباق والمناشف مع الآخرين، خصوصًا إذا كانوا مرضى.
- تطهير الأسطح: نظّف وعقّم الأسطح التي تُلمس بشكل متكرر في المنزل ومكان العمل للحد من انتشار الجراثيم.
متى يجب استشارة الطبيب؟
بينما غالبًا ما يكون ارتفاع الخلايا اللمفاوية مؤشرًا على استجابة مناعية طبيعية، فمن المهم الانتباه لبعض العلامات التي تستدعي زيارة الطبيب لتقييم الحالة:
- إذا كنت تعاني من عدوى تبدو مستمرة أو لا تستجيب للعلاجات المنزلية المعتادة.
- إذا لاحظت ظهور أعراض جديدة أو غير مبررة، أو إذا تفاقمت الأعراض الموجودة بمرور الوقت.
- إذا كان لديك ارتفاع في الخلايا اللمفاوية تم اكتشافه بالصدفة، والطبيب يرى ضرورة للمتابعة والتحقيق في السبب الكامن.
تذكر دائمًا أن التشخيص المبكر يتيح العلاج الفعال ويساعد على الحفاظ على صحتك.
الخلاصة
في الختام، يُعد ارتفاع الخلايا اللمفاوية مؤشرًا حيويًا على نشاط جهاز المناعة. في معظم الحالات، يشير إلى أن جسمك يحارب بنجاح عدوى بسيطة. ومع ذلك، من الضروري دائمًا فهم السبب الكامن وراء هذا الارتفاع من خلال الاستشارة الطبية والفحوصات اللازمة.
ابقَ على دراية بجسمك، ولا تتردد في طلب المشورة الطبية عند الحاجة، فصحتك هي أولويتك القصوى.